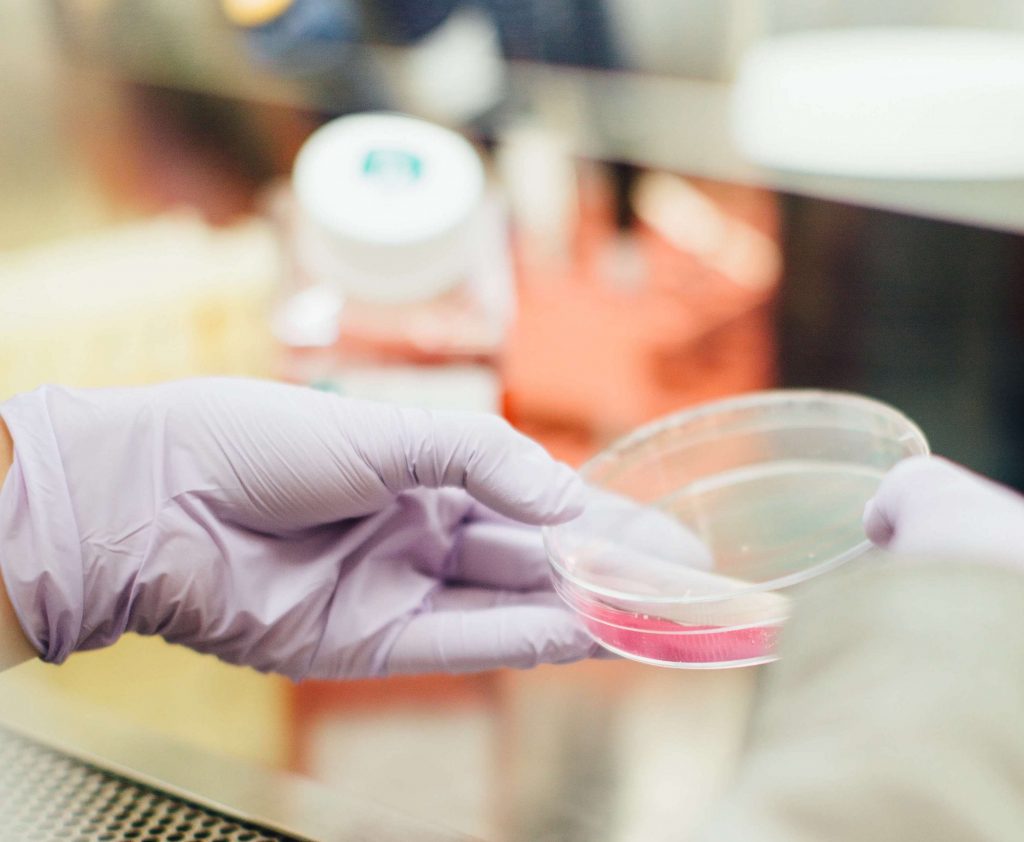
covid y alopecia

30 Abr ¿Existe alguna relación entre el virus SARS-COV2 y la alopecia androgenética?
La dermatóloga Alba Gomez, especialista en regeneración capilar de Intituto Medico Ricart en Ruber Internacional Paseo de la Habana ha participado en el estudio publicado a nivel mundial donde participan los mejores especialistas referentes en medicina capilar y establecen las siguientes conclusiones:
- Existe una posible relación entre la alopecia androgenética y la enfermedad por coronavirus.
- La relación se establece entre las hormonas sexuales masculinas o andrógenos y la entrada del virus en las células pulmonares, con diferentes moléculas intermediarias.
- Los varones han demostrado ser un grupo de riesgo para padecer la enfermedad, con mayor gravedad y mayor tasa de fallecimientos. Esto podría sustentarse en los niveles superiores de andrógenos.
- La alopecia androgenética es una enfermedad en la que existe mayor sensibilidad y expresión de andrógenos, por lo que podría ayudar a identificar de forma sencilla a los pacientes de mayor riesgo para la COVID-19.
- Los pacientes con formas severas de alopecia androgenética, enfermedad de diagnóstico sencillo y visual, serían susceptibles a padecer formas de la enfermedad por coronavirus más graves.
- Entre más de 100 pacientes ingresados por neumonía por coronavirus durante la pandemia, se han detectado porcentajes superiores de alopecia androgenética severa respecto a la población general.
- Hay varios estudios en marcha sobre esta hipótesis desarrollada por el dermatólogo estadounidense Dr. Andy Goren.
- Por el momento los estudios sobre los que se apoya esta relación son in vitro (en laboratorio), pero podrían aportar mucha luz para entender el pasado y mejorar el futuro de la enfermedad.
- Si las investigaciones sobre esta teoría continúan en el futuro, se podría plantear el papel protector de algunos fármacos empleados para el tratamiento de la alopecia, como el finasteride, de cara la prevención de las formas severas de esta infección.
- Se debe plantear una línea de investigación, sobre el papel de estos andrógenos en mujeres con la COVID-19, ya que sus niveles de andrógenos no son nulos y pueden también padecer enfermedades que los incrementen.
¿Cómo hemos llegado a estas conclusiones?
Aunque aparentemente sean dos patologías de los más dispares entre sí, podría existir un nexo de unión entre ellas que además ayudaría a entender mejor algunos aspectos de la pandemia actual por la COVID-19, y podría facilitar en el futuro la detección de pacientes con mayor riesgo de enfermar a partir de algo tan visible como es el cabello.
El artículo publicado recientemente en una revista dermatológica internacional de gran impacto, y firmado por algunos de los principales dermatólogos especialistas en tricología entre los que me encuentro, se encuadra en una serie de publicaciones científicas que intentan aportar más luz para lograr entender el mecanismo de infección del SARS-COV2, más conocido como coronavirus.
El doctor Andy Goren, dermatólogo estadounidense que ejerce su profesión en la ciudad de Irvine, en el estado de california, es el promotor de esta teoría que relacionaría la entrada del virus a las células pulmonares con los receptores de andrógenos, y en última instancia, permitiría identificar a los pacientes de mayor riesgo de sufrir formas graves de la COVID-19 a partir de la situación capilar de alopecia.
Los andrógenos engloban a una serie de hormonas sexuales masculinas, lo cual no implica que no existan también en el sexo femenino, aunque en menor medida.
Ejercen su acción sobre sus receptores específicos, denominados receptores androgénicos, que se localizan en diferentes órganos del cuerpo. En los estudios in vitro (realizados en laboratorio), se ha demostrado una relación entre una molécula denominada TMPRSS2 y la entrada del virus en las células pulmonares. En último término, la producción de esta molécula estaría determinada por los andrógenos mencionados.
Se puede por tanto establecer una relación directa entre la entrada del virus en las células pulmonares y las hormonas sexuales masculinas o andrógenos, de tal modo que una mayor expresión o cantidad de andrógenos predispondrían a una mayor entrada de los virus en las células pulmonares, y por lo tanto un cuadro de infección de coronavirus de mayor gravedad.
Hasta la fecha actual, esta teoría está solo sobre el papel y en los estudios de laboratorio pero la relación que establece puede tener consecuencias importantes en el futuro y puede ayudar a explicar algunos acontecimientos del pasado.
Por un lado, se han identificado algunas enfermedades que podrían predisponer a un mayor riesgo de infección y a cuadros más graves de enfermedad, como por ejemplo las enfermedades pulmonares o cardiovasculares.
Sin embargo, también se ha identificado un mayor número de hombres contagiados respecto a mujeres, así como un mayor número de pacientes varones en estado de gravedad y de fallecimientos, respecto a las mujeres. Esta mayor afectación al sexo masculino podría ser explicada con la teoría explicada previamente.
Por otro lado, si seguimos en la línea de lo explicado, podríamos identificar a los pacientes con mayores niveles de andrógenos, como pacientes de mayor riesgo para sufrir formas graves de la COVID-19.
Existen diferentes enfermedades en las que sabemos que los niveles de andrógenos, o bien la susceptibilidad a los mismos, están aumentados, sin embargo todas ellas requieren estudios adicionales para su diagnóstico y por lo tanto no son útiles para detectar fácilmente a los varones en riesgo. Sin embargo, la alopecia androgenética es una enfermedad externa y visible, sencilla de diagnosticar, que no requiere grandes estudios adicionales ni pruebas invasivas y en la que conocemos se cumple esta mayor sensibilidad a las hormonas masculinas.
Por ello, si se confirma esta teoría presentada, podríamos señalar a los varones que presentan un grado elevado de alopecia androgenética como posibles pacientes de mayor riesgo en la infección por coronavirus.
En este sentido, se ha estudiado a más de 100 pacientes ingresados con cuadros de neumonía por coronavirus, y se ha detectado un porcentaje mayor de alopecia androgenética que en la población general, lo que apoya la teoría propuesta.
Finalmente, yendo un paso más hacia el futuro, y todavía sin haber puesto en marcha estudios al respecto, pero basándonos en estos conocimientos teóricos, se podría plantear que los fármacos empleados para el tratamiento de la alopecia androgenética, con acción anti hormonas sexuales masculinas, podrían tener un papel protector en la enfermedad por SARS-COV2, lo que abre la puerta a nuevas posibilidades terapéuticas o de prevención de esta nueva pandemia

Dermatóloga especialista en Regeneración Capilar y responsable de la unidad de medicina capilar de
Instituto Médico Ricart en Ruber Internacional Paseo de la Habana 43

No hay comentarios